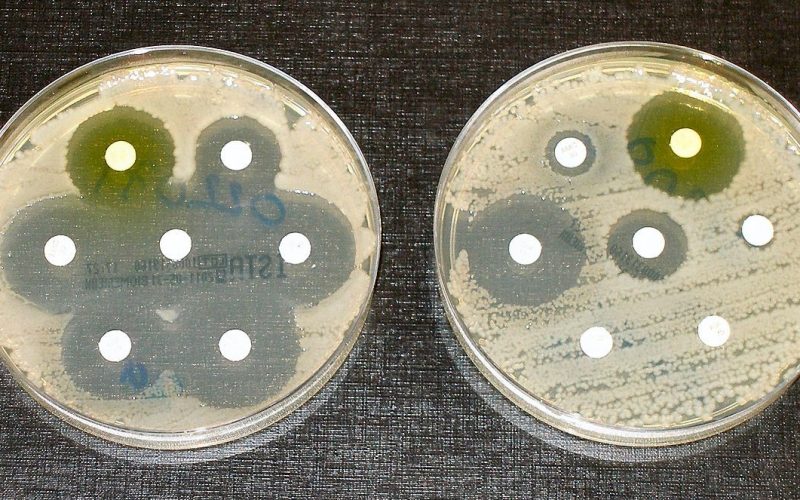

“Review on Antimicrobial Resistance” raporu, durumun ne kadar vahim olduğunu gözler önüne serdi. Rapora göre 2050 yılına dek dünya genelinde tedavi edilemeyen enfeksiyonlar yüzünden her yıl on milyon kişi ölecek. Rapor ile ilgili çalışmalar 2014’te İngiliz hükumetinin isteği üzerine başladı. Çalışmaların başlamasından sonraki iki yıl içinde antibiyotikle tedavi edilemeyen hastalıklar yüzünden bir milyonun üzerinde kişi hayatını kaybetti deniyor. Ayrıca Colistin gibi rezervde tutulan kuvvetli antibiyotiklere karşı da direnç tespit edilmiş.
Ana sorunlardan biri yeterli miktarda yeni antibiyotiklerin üretilemiyor olması. Soruna bir çözüm bulamazsak Ortaçağ’a geri döneriz ve çok sayıda insan hayatını kaybeder diyor araştırmacılar. Öyle ki parmakta açılan küçük bir kesik yarası bile antibiyotik öncesi devirlerdeki ameliyatlar gibi hayatı tehdit edecek hale gelebilecek. Uzmanlar bu yüzden sorunun hızlı bir şekilde bilinçlendirilmesi için acil adımların atılmasını öneriyor. Birçok insan riskleri küçümsüyor, örneğin tarım ekonomisinde de antibiyotik kullanımının azaltılması için bir bilgilendirme kampanyası şart diyen uzmanların önerileri şöyle:
“Yeni antibiyotikler üzerinde çalışan firmalara bir milyar dolarlık destek sağlanmalı. Araştırma yapmayanlar bir fona ödeme yapmalı. Hedef, uluslararası siyasi ve endüstriyel işbirliği olmalı.”
1980’li yıllardan bu yana yeni antibiyotik grupları keşfedilmemişti. Ekonomist Jim O’Neal, antibiyotiği hastalıkların tedavisinden çok hayvanların yetiştirilmesinde kullanan ABD’yi uyarıyor. ABD’deki antibiyotiklerin %70’i hayvanlarda kullanılıyor. Bu yüzden de dirençli bakterilerin insanlar arasında yaygınlaşma tehlikesi büyük. O’Neal ayrıca virüslere bağlı enfeksiyonlarda antibiyotik yazılmamasını da öneriyor.
Kaynak:
1.http://amr-review.org/
2.www.bbc.com/news/health-36321394